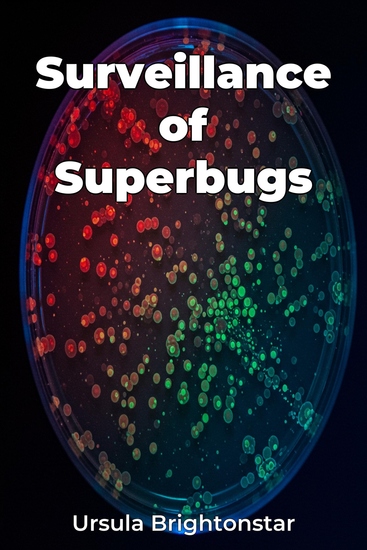

Surveillance of Superbugs
Ursula Brightonstar
Traducteur A AI
Maison d'édition: Publifye
Synopsis
Surveillance of Superbugs addresses the urgent global threat of antibiotic resistance by focusing on the critical role of surveillance in tracking and combating these "superbugs". The book highlights how the overuse of antibiotics has accelerated the evolution and spread of drug-resistant bacteria, creating a need for innovative strategies and international collaboration. Readers will gain insights into the molecular mechanisms that drive antibiotic resistance and the global epidemiology of these dangerous pathogens. The book explores various surveillance systems used worldwide, from traditional methods to advanced molecular diagnostics like whole-genome sequencing. It emphasizes the importance of robust, coordinated, and data-driven surveillance for effective intervention. By providing an in-depth analysis of surveillance tools and strategies, the book offers a unique perspective on how to monitor resistant bacteria and make informed decisions in public health and clinical practice. Starting with fundamental concepts of antibiotic resistance and epidemiology, the book progresses through methods of detection, examples of surveillance programs, and finally, a vision for future integrated data systems. This approach makes complex topics accessible to scientists, healthcare professionals, and policymakers, offering practical applications for improving infection control and promoting responsible antibiotic use.














